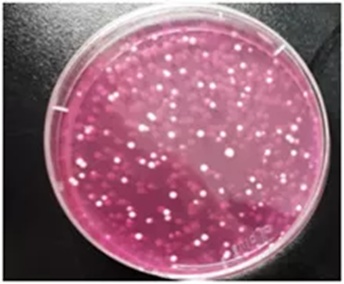

当初冲动“跺手”买多了的化妆品
到了临期甚至过期才只用了个角
到底是扔垃圾桶
还是“废物利用”涂到老公脸上?

让咱们来看看此前上海市消保委委托上海市质量监督检验技术研究院/国家保洁产品质量检验检测中心做的实验!
实验对象选择了亲们最爱屯的护肤品之一——面膜。由工作人员友情提供过期不同时间的面膜,五款面膜的过期时间依次为:2017年7月,2020年10月,2020年12月,2021年3月和2021年5月。
这里是严肃的实验
本次实验依照《化妆品安全技术规范》(2015年版)进行微生物检测。
我国规定眼部化妆品、口唇化妆品和儿童化妆品的菌落总数不得超过500CFU/g,其他普通化妆品的菌落总数不得超过1000CFU/g,霉菌和酵母菌总数不得超过100CFU/g,耐热大肠菌群、金黄色葡萄球菌和铜绿假单胞菌为不得检出。
结果显示,过期4年的面膜毫无悬念的超标了!它的菌落总数为5.5×104CFU/g,霉菌总数为5.9×104CFU/g;另一款是过期3个月的面膜也翻车了,它的菌落总数≥3×105CFU/g,超过国家限制整整300倍!
幸运的是,5款产品耐热大肠菌群、金黄色葡萄球菌和铜绿假单胞菌均未检出。

长满菌落的培养皿
由图可见,过期化妆品的微生物超标情况和过期时间未必有对应关系,但是过期化妆品的安全性确实是存在隐患的,可能会引起细菌感染,或者产生过敏的情况哦。
你以为的护肤并不是你以为的护肤
许多勤俭持家的宝宝不信邪,说我用过过期产品还不是好好的?好的,也许你涂的过期产品并没有什么不良反应,但你所做的护肤动作可能没效果了。
毕竟菌落生长也是需要营养的,那么它们繁衍后代的这个营养从哪儿来呢?当然就是从面膜里的成分里来了。
想象一下,细菌一边消耗护肤品里的营养成分,一边代谢出产物,随着时间的推移,营养成分越来越少,代谢产物越来越多,到最后你就在涂代谢产物啊!虽然红极一时的二裂酵母发酵产物也是微生物发酵所得,但劝你还是不要期待你手上过期面膜里的微生物也能生产出类似的护肤功效成分。
当然也有可能过保后的产品微生物指标是合格的,就像试验中的另三个产品。因此,建议大家还是在有效期内使用。
温馨小贴士
这里特别提醒一下,保质期不单单有完整包装的保质期,还有开瓶保质期这个概念。部分进口产品包装上印的数字就是开瓶保质期了。(如下图)

通常普通化妆品在未开封的情况下可以保存2年不变质不受污染,但是一旦开封,产品的质量就会随着与人体的接触、与空气的接触而改变,防腐剂的添加可以一定程度上抑制微生物的增值,但是当微生物的浓度超过一定量后,防腐剂也无济于事,因此开瓶保质期就是对这一问题进行了警示。
国产化妆品目前还没有要求标识开瓶保质期,因此建议开封后尽快用完,用久的难免不记得什么时候开封,建议各位在瓶身做个标注。
来源:上海市场监管
编辑:沈莉娜